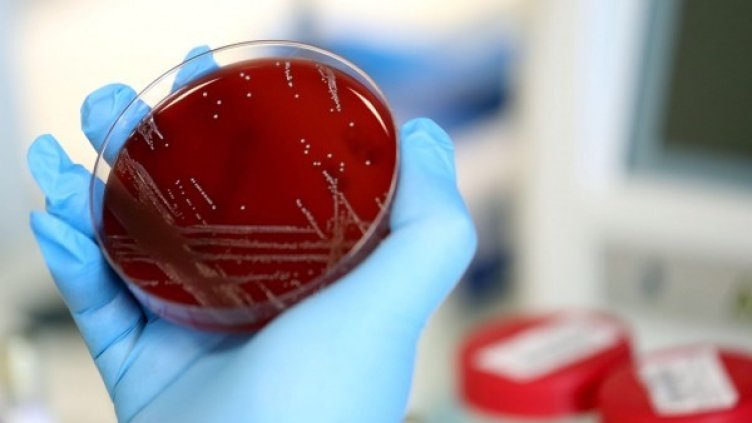
Снимка: БГНЕС

Първата държава засегната от COVID-19 - Китай, проявява хладнокръвие след съобщението за открития там нов щам свински грипен вирус с характеристики на потенциална пандемия, предаде АФП.
Вирусът G4 произхожда генетично от щама H1N1, предизвикал пандемия през 2009 г.
A new strain of the H1N1 swine flu virus is spreading silently in workers on pig farms in China and should be “urgently” controlled to avoid another pandemic, a team of scientists says in a new study https://t.co/r5XIDTVuDj
— The New York Times (@nytimes) June 30, 2020
Запитан за него, Чжао Лицзян, говорител Китай ще продължи да "наблюдава болестта, ще съобщи за нея (ако е необходимо) и ще я лекува своевременно".
"Изводите на експертите са, че цитираната в статията извадка е малка и непредставителна", каза Чжао Лицзян.
Статия за изследването на специалисти от китайски университети и от китайския Център за профилактика и борба със заболяванията, беше публикувана в американското сп. "Протоколи на Националната академия на науките" (PNAS), предаде "Дарик".
От 2011 до 2018 г. те са взели 30 000 назални проби от прасета в кланици в 10 китайски провинции и в една ветеринарна болница. Изолирани са 179 вируса свински грип.
Според изследователите заразилите се хора, които са били контактни с прасетата, са сравнително много - 10,4%. Те мислят, че вирусът G4 вече е преминал у хора, но няма доказателства дали може да се предава от човек на човек.
Това се случи Dnes, за важното през деня ни последвайте и в Google News Showcase.

Министерството на финансите преотвори за трети път емисия 10-годишни ДЦК
Министерството на финансите преотвори за трети път емисия 10-годишни ДЦК  Сенчестият руски флот ще бъде обхванат от още санкции на ЕС
Сенчестият руски флот ще бъде обхванат от още санкции на ЕС  Даниел Ръсел: Тръмп се нуждае от помощта на Пекин, за да накара Иран да преговаря
Даниел Ръсел: Тръмп се нуждае от помощта на Пекин, за да накара Иран да преговаря  Wall Street започва търговията с леки спадове след отказа на Тръмп към Иран*
Wall Street започва търговията с леки спадове след отказа на Тръмп към Иран*  България е сред лидерите в Европа по технологични решения в областта на имотите
България е сред лидерите в Европа по технологични решения в областта на имотите  ЕК очаква мнения за предложените промени в схемата за въглеродни емисии до 8 юни
ЕК очаква мнения за предложените промени в схемата за въглеродни емисии до 8 юни 
 Мъж загина след падане в София, линейка дошла след 24 минути
Мъж загина след падане в София, линейка дошла след 24 минути  "Справедлива цена" и солени глоби: "Прогресивна България" погва нелоялните търговци
"Справедлива цена" и солени глоби: "Прогресивна България" погва нелоялните търговци  В "Денят ON AIR" днес от 19:15 часа: Ще подействат ли мерките срещу високите цени?
В "Денят ON AIR" днес от 19:15 часа: Ще подействат ли мерките срещу високите цени?  Разбиха схема за платени секс услуги в Бургас
Разбиха схема за платени секс услуги в Бургас  "Възраждане": Връщането на лева ще намали инфлацията
"Възраждане": Връщането на лева ще намали инфлацията  Любо Пенев: Животът ни изправя пред битки, за които никой не е напълно готов
Любо Пенев: Животът ни изправя пред битки, за които никой не е напълно готов 
 Ще играе ли Меси на Мондиал 2026? Селекционерът на Аржентина даде отговор
Ще играе ли Меси на Мондиал 2026? Селекционерът на Аржентина даде отговор  Цървена звезда показа на Левски, ЦСКА и Лудогорец как се прави
Цървена звезда показа на Левски, ЦСКА и Лудогорец как се прави  Светльо Вуцов изригна мощно за Левски
Светльо Вуцов изригна мощно за Левски  Важна новина за феновете на Левски и ЦСКА
Важна новина за феновете на Левски и ЦСКА  Двама национали подписаха в Гърция
Двама национали подписаха в Гърция  Джесика Малена – половинката на Иммобиле
Джесика Малена – половинката на Иммобиле 
 Поверия за 12 май – Герман Градушкар
Поверия за 12 май – Герман Градушкар  Дневен хороскоп за 12 май, вторник
Дневен хороскоп за 12 май, вторник  Три топ хардкор банди откриват лятната сцена в Борисовата градина
Три топ хардкор банди откриват лятната сцена в Борисовата градина  3 грешки, които допускате, когато приготвяте паста
3 грешки, които допускате, когато приготвяте паста  Day Off: Family Time посреща ваканцията с игри, семейни активности и големи награди
Day Off: Family Time посреща ваканцията с игри, семейни активности и големи награди  4 тренда при обувките за пролет-лято 2026
4 тренда при обувките за пролет-лято 2026 
 продава, Склад, 3300 m2 Пловдив област, с.Стряма, 4350000 EUR
продава, Склад, 3300 m2 Пловдив област, с.Стряма, 4350000 EUR  продава, Двустаен апартамент, 67 m2 Бургас област, гр.Ахелой, 85000 EUR
продава, Двустаен апартамент, 67 m2 Бургас област, гр.Ахелой, 85000 EUR  продава, Двустаен апартамент, 67 m2 Пловдив, Христо Смирненски, 72974 EUR
продава, Двустаен апартамент, 67 m2 Пловдив, Христо Смирненски, 72974 EUR  продава, Тристаен апартамент, 103 m2 Стара Загора, Самара 3, 135000 EUR
продава, Тристаен апартамент, 103 m2 Стара Загора, Самара 3, 135000 EUR  продава, Къща, 80 m2 Стара Загора област, с.Столетово, 15000 EUR
продава, Къща, 80 m2 Стара Загора област, с.Столетово, 15000 EUR  продава, Парцел, 1430 m2 Стара Загора област, с.Михайлово, 13000 EUR
продава, Парцел, 1430 m2 Стара Загора област, с.Михайлово, 13000 EUR 
 Любо Пенев с емоционален пост за предстоящия Мач на надеждата
Любо Пенев с емоционален пост за предстоящия Мач на надеждата  Навръх 35-тата си годишнина ПГИТ „Д-р Иван Богоров“ разкри STEM център
Навръх 35-тата си годишнина ПГИТ „Д-р Иван Богоров“ разкри STEM център  "Прогресивна България" с мерки срещу високите цени
"Прогресивна България" с мерки срещу високите цени  Научноизследователският кораб ще направи мониторинг за чистотата на морската вода
Научноизследователският кораб ще направи мониторинг за чистотата на морската вода  Хороскоп за 12 май 2026
Хороскоп за 12 май 2026  Хванаха за ден 35-ма шофьори с алкохол или наркотици
Хванаха за ден 35-ма шофьори с алкохол или наркотици 
 Космически апарат на НАСА ще използва Марс, за да промени траекторията си
Космически апарат на НАСА ще използва Марс, за да промени траекторията си  3D принтирането ще направи ракетните двигатели по-гъвкави и безопасни
3D принтирането ще направи ракетните двигатели по-гъвкави и безопасни  Апокалиптични прогнози през вековете: Култ предрече края на света за 2026 г.
Апокалиптични прогнози през вековете: Култ предрече края на света за 2026 г.  Телескопът „Джеймс Уеб“ откри гигантска неподвижна галактика в ранната Вселена
Телескопът „Джеймс Уеб“ откри гигантска неподвижна галактика в ранната Вселена  Какво ще стане, ако Слънцето изчезне за 1 секунда?
Какво ще стане, ако Слънцето изчезне за 1 секунда?  Коя е най-горещата точка на Земята: Държавата с най-много вулкани в света
Коя е най-горещата точка на Земята: Държавата с най-много вулкани в света 











